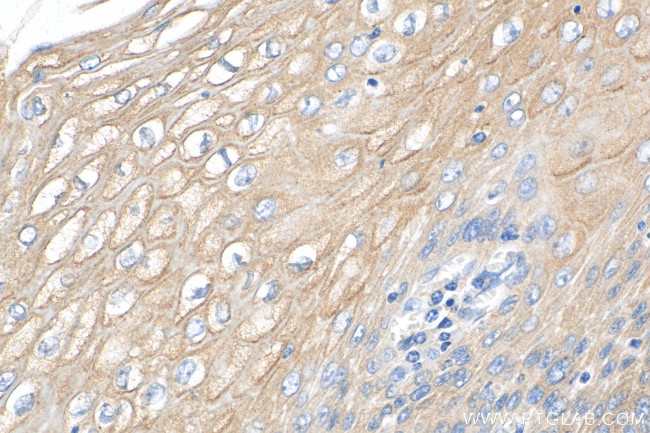
KRT80 Antibody in Immunohistochemistry (Paraffin) (IHC (P))

Search
Proteintech
KRT80 Polyclonal Antibody, Biotin Plus
{{$productOrderCtrl.translations['antibody.pdp.commerceCard.promotion.promotions']}}
{{$productOrderCtrl.translations['antibody.pdp.commerceCard.promotion.viewpromo']}}
{{$productOrderCtrl.translations['antibody.pdp.commerceCard.promotion.promocode']}}: {{promo.promoCode}} {{promo.promoTitle}} {{promo.promoDescription}}. {{$productOrderCtrl.translations['antibody.pdp.commerceCard.promotion.learnmore']}}
产品信息
BIOTIN-16835
种属反应
宿主/亚型
分类
类型
抗原
偶联物
形式
纯化类型
保存液
内含物
保存条件
运输条件
产品详细信息
Immunogen sequence: MACRSCVVGF SSLSSCEVTP VGSPRPGTSG WDSCRAPGPG FSSRSLTGCW SAGTISKVTV NPGLLVPLDV KLDPAVQQLK NQEKEEMKAL NDKFASLIGK VQALEQRNQL LETRWSFLQG QDSAIFDLGH LYEEYQGRLQ EELRKVSQER GQLEANLLQV LEKVEEFRIR YEDEISKRTD MEFTFVQLKK DLDAECLHRT ELETKLKSLE SFVELMKTIY EQELKDLAAQ VKDVSVTVGM DSRCHIDLSG IVEEVKAQYD AVAARSLEEA EAYSRSQLEE QAARSAEYGS SLQSSRSEIA DLNVRIQKLR SQILSVKSHC LKLEENIKTA EEQGELAFQD AKTKLAQLEA ALQQAKQDMA RQLRKYQELM NVKLALDIEI ATYRKLVEGE EGRMDSPSAT VVSAVQSRCK TAPSLPYPLC SL
靶标信息
Keratins are intermediate filament proteins responsible for the structural integrity of epithelial cells and are subdivided into epithelial keratins and hair keratins. This gene's expression profile shows that it encodes a type II epithelial keratin, although structurally the encoded protein is more like a type II hair keratin. This protein is involved in cell differentiation, localizing near desmosomal plaques in earlier stages of differentiation but then dispersing throughout the cytoplasm in terminally differentiating cells. The type II keratins are clustered in a region of chromosome 12q13. Two transcript variants encoding two different fully functional isoforms have been found for this gene.
仅用于科研。不用于诊断过程。未经明确授权不得转售。
篇参考文献 (0)
生物信息学
蛋白别名: CK-80; Cytokeratin-80; K80; keratin 80, type II; keratin b20; Keratin, type II cytoskeletal 80; Keratin-80; type II keratin; type II keratin Kb20; type II keratin-20; Type-II keratin Kb20
基因别名: 1200016G03Rik; 2310041I20Rik; Kb2; KB20; KRT80
UniProt ID: (Human) Q6KB66, (Mouse) Q0VBK2, (Rat) Q6IMF1
Entrez Gene ID: (Human) 144501, (Mouse) 74127, (Rat) 315318